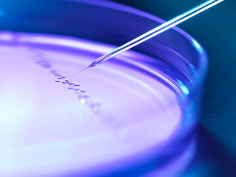
image.png

太康永興醫院幹細胞療法怎麽樣,有效果嗎
2024-11-16 16:19:47 來源: 小編 咨詢醫生
本文将深入探讨太康永興醫院幹細胞療法的專業水平、治療效果以及其在醫學領域的應用前景。
幹細胞療法是一種利用幹細胞修複和再生受損組織的技術,近年來在國内外醫學界備受關注。太康永興醫院作爲我國一家專業醫療機構,其幹細胞療法的效果和口碑如何呢?下面我們來詳細了解。
一、太康永興醫院幹細胞療法的專業水平
太康永興醫院擁有一支專業的醫療團隊,其中包括多位在幹細胞研究領域具有豐富經驗的專家。醫院引進了國際先進的幹細胞培養技術,并嚴格按照國家相關規定和标準進行操作。此外,醫院還與國内外多家知名研究機構保持緊密合作,不斷優化和提升幹細胞療法的治療效果。
二、太康永興醫院幹細胞療法的效果
1.安全性高:幹細胞療法具有較低的副作用,患者在接受治療後不易出現排斥反應。太康永興醫院在幹細胞療法方面積累了豐富的經驗,使得治療過程更加安全可靠。
2.治療範圍廣:幹細胞療法可以應用于多種疾病的治療,如神經系統疾病、心血管疾病、肝硬化、骨折愈合等。太康永興醫院的幹細胞療法已成功治愈了衆多患者,爲他們帶來了健康。
3.療效顯著:幹細胞療法能夠有效修複受損組織,促進細胞再生,從而改善患者的症狀和體征。太康永興醫院在治療過程中,根據患者的具體情況制定個性化的治療方案,确保治療達到最佳效果。
4.恢複快:幹細胞療法具有較快的恢複速度,患者在治療後短時間内即可恢複正常生活。
三、太康永興醫院幹細胞療法在醫學領域的應用前景
随着幹細胞療法在國内外醫學界的不斷發展和完善,其在臨床應用前景十分廣闊。太康永興醫院作爲一家專業醫療機構,将繼續加大研究力度,探索幹細胞療法在更多疾病領域的應用。未來,幹細胞療法有望爲更多患者帶來希望和康複。
總之,太康永興醫院的幹細胞療法在專業水平、治療效果以及應用前景方面都具有較高優勢。如果您或您的家人朋友正面臨相關疾病的困擾,不妨嘗試咨詢太康永興醫院的專家,了解幹細胞療法是否适合您的情況。
-
下一頁: 幹細胞卵巢早衰治療有用嗎,效果明不明顯
- 2024-11-25幹細胞再生療法的缺點是什麽,如何規避這些風險
- 2024-12-07幹細胞療法治腸癌嗎,治療成功率如何
- 2024-11-21全球上市的幹細胞療法進展如何,能否治療哪些疾病
- 2024-10-07嘉興肝硬化幹細胞功效如何,能否有效改善病情
- 2024-08-08幹細胞牙齒再生技術,幹細胞牙齒再生技術能實現嗎
- 2024-09-10幹細胞治療陽痿,重拾男性勃起功能
- 2024-10-11打一針幹細胞要多少錢?影響因素有哪些?
- 2024-09-06幹細胞介入治療胃癌效果如何,費用大概多少
- 2024-09-05如何采集造血幹細胞,造血幹細胞采集流程詳解
- 2024-09-27有人在廣州貝拉國際回輸幹細胞嗎
- 2024-08-03幹細胞移植是什麽意思,幹細胞移植的十大好處
- 2024-09-07幹細胞技術高度近視能恢複嗎,何時可以臨床
- 2024-08-23什麽是造血幹細胞移植,移植流程步驟解讀
- 2024-09-17捐造血幹細胞對身體有害嗎,捐造血幹細胞好處和壞處
- 2024-09-11幹細胞再生技術哪個國家最先進,綜合排名前五名
- 2024-09-28國家批準的幹細胞醫院有哪幾家,這十家醫院榜上有名
- 2024-09-04植物幹細胞的價格及影響因素
- 2024-10-07幹細胞研究有哪些重大突破?對未來有何啓示?
